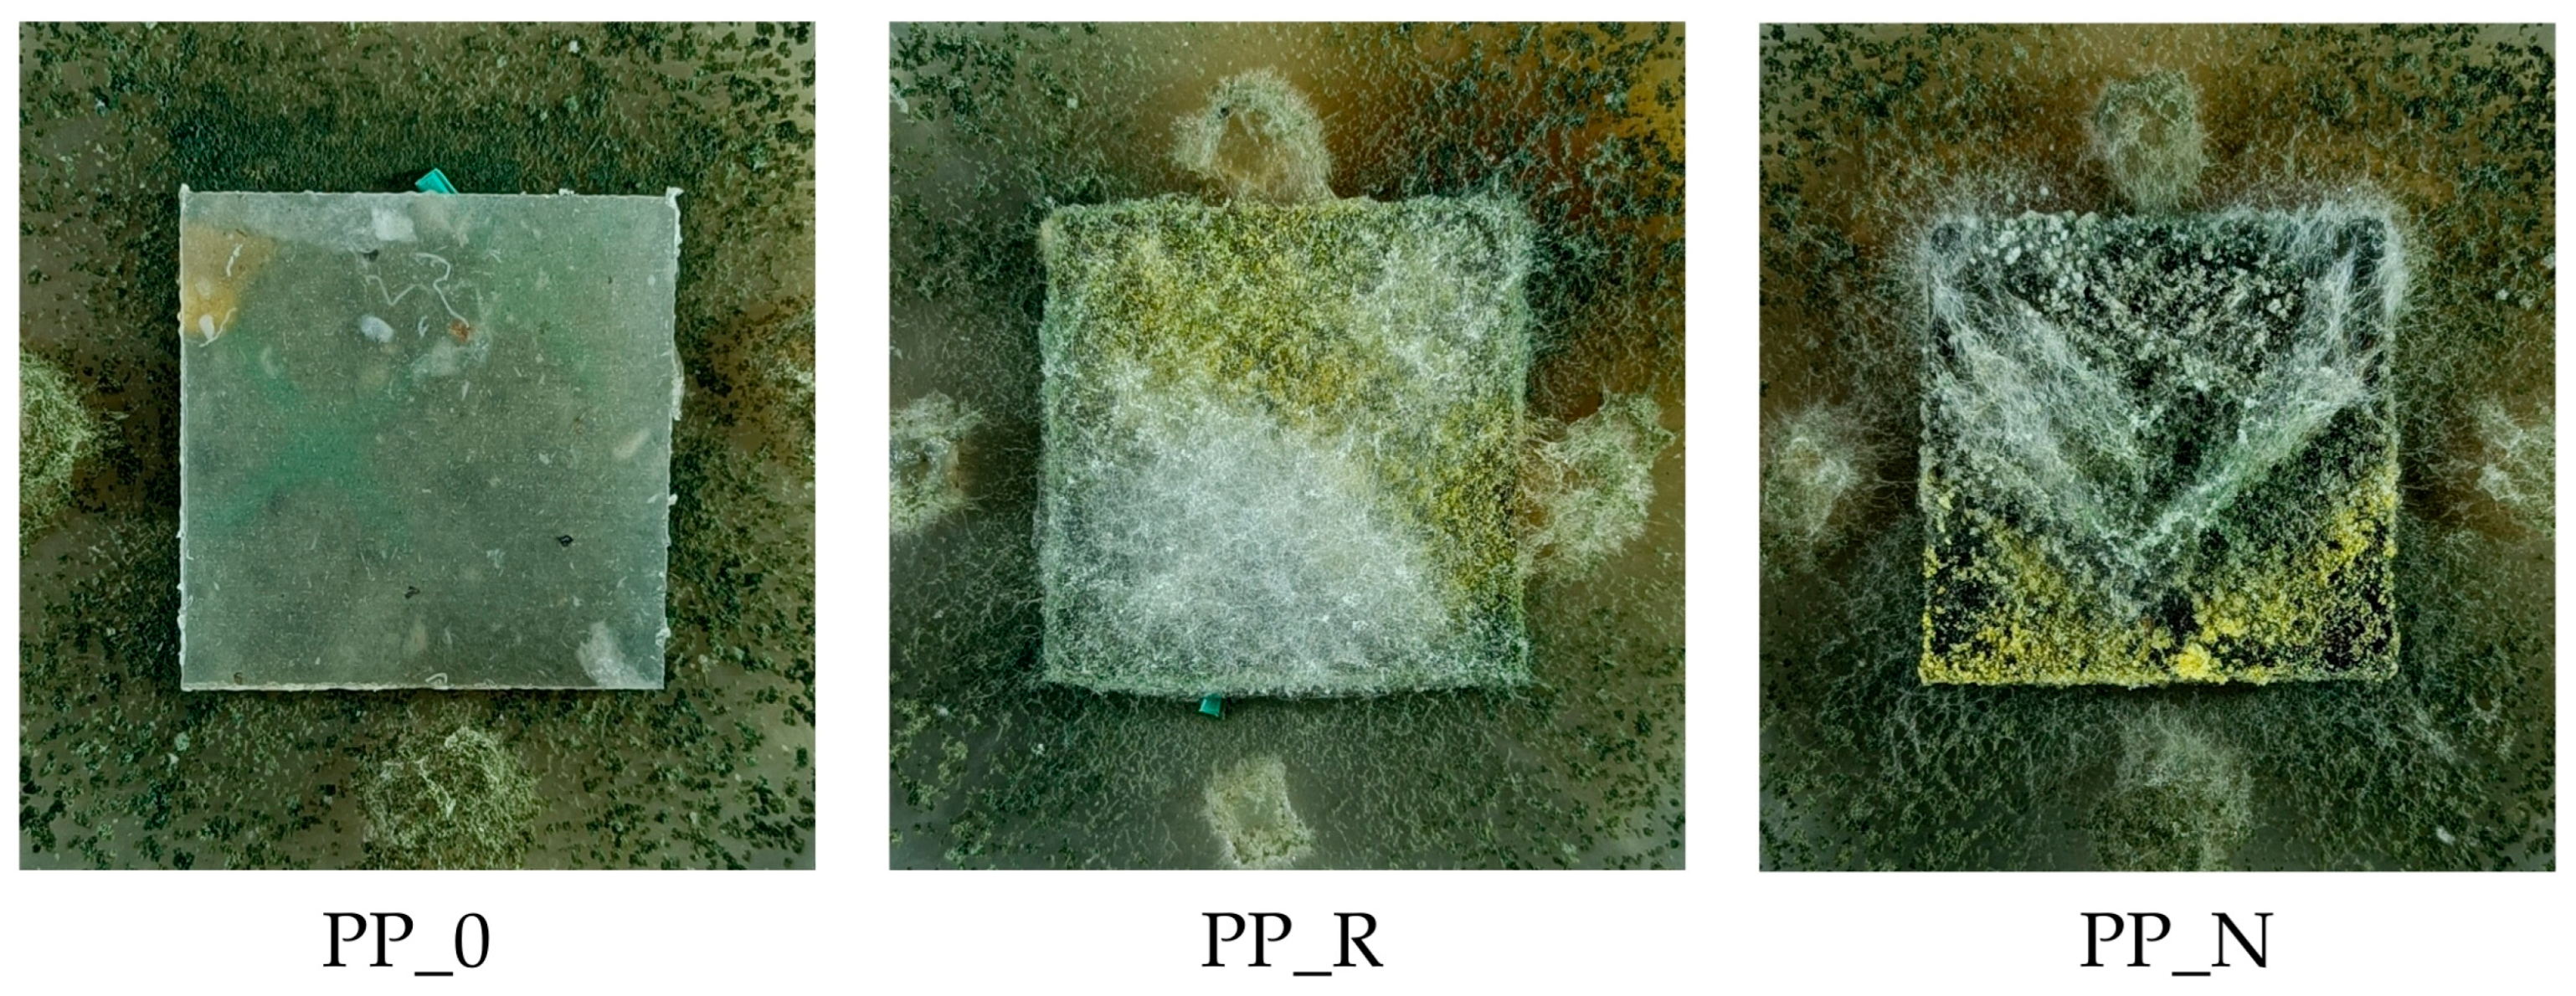
Polymers 16 03557 g017

Characterization of Composites from Post-Consumer Polypropylene and Oilseed Pomace Fillers
Abstract
1. Introduction
2. Materials and Methods
2.1. Preparation of Biocomposites
- PP_0: post-consumer polypropylene;
- PP_N: PP + nigella sativa pomace;
- PP_R: PP + rapeseed pomace.
2.2. Quality Parameters of Composites
2.2.1. Density and Mechanical Properties
2.2.2. Surface Roughness
2.2.3. Contact Angle
2.2.4. Water Absorption and Thickness Swelling
- m0—mass of sample, mn—mass of sample after soaking in water, n—time, n ∈ (2, 24).
2.2.5. Fourier-Transform Infrared Spectroscopy (FTIR)
2.2.6. Thermal Properties of Composites
2.2.7. SEM Analysis
2.2.8. Growth of Fungi
2.3. Test Standards
3. Results
3.1. Density and Mechanical Properties Results
3.2. Surface Roughness Results
3.3. Contact Angle Results
3.4. Water Absorption and Thickness Swelling Results
3.5. Fourier-Transform Infrared Spectroscopy (FTIR) Results
- R_0: rapeseed seed pomace;
- N_0: sunflower seed pomace.
3.6. Results of Thermal Properties of Composites
3.7. Results of SEM Analysis
3.8. Growth of Fungi Results
4. Discussion
5. Conclusions
Author Contributions
Funding
Institutional Review Board Statement
Data Availability Statement
Acknowledgments
Conflicts of Interest
References
- Gwon, J.-G.; Cho, H.-J.; Lee, D.; Choi, D.-H.; Lee, S.; Wu, Q.; Lee, S.-Y. Physicochemical and Mechanical Properties of Polypropylene-Cellulose Nanocrystal Nanocomposites: Effects of Manufacturing Process and Chemical Grafting. Bioresources 2018, 13, 1619–1636. [Google Scholar] [CrossRef]
- Zhiltsova, T.; Campos, J.; Costa, A.; Oliveira, M.S.A. Sustainable Polypropylene-Based Composites with Agro-Waste Fillers: Thermal, Morphological, Mechanical Properties and Dimensional Stability. Materials 2024, 17, 696. [Google Scholar] [CrossRef]
- Flores-Hernández, C.G.; López-Barroso, J.; Ramos-Galván, C.E.; Salazar-Cruz, B.A.; Chávez-Cinco, M.Y.; Rivera-Armenta, J.L. Development of a Composite Filament Based on Polypropylene and Garlic Husk Particles for 3D Printing Applications. Appl. Sci. 2024, 14, 9139. [Google Scholar] [CrossRef]
- Nahar, S.; Khan, R.A.; Dey, K.; Sarker, B.; Das, A.K.; Ghoshal, S. Comparative Studies of Mechanical and Interfacial Properties between Jute and Bamboo Fiber-Reinforced Polypropylene-Based Composites. J. Thermoplast. Compos. Mater. 2012, 25, 15–32. [Google Scholar] [CrossRef]
- Wang, T.; Rodriguez-Uribe, A.; Misra, M.; Mohanty, A.K. Sustainable Carbonaceous Biofiller from Miscanthus: Size Reduction, Characterization, and Potential Bio-composites Applications. Biorecources 2018, 13, 3720–3739. [Google Scholar] [CrossRef]
- Ray, R.; Das, S.N. Biodegradation Behaviour of the Composite Consisting of Polypropylene and Bauhinia Vahlii Fiber. ChemistrySelect 2024, 9, e202402089. [Google Scholar] [CrossRef]
- Nourbakhsh, A.; Ashori, A.; Kazemi Tabrizi, A. Characterization and Biodegradability of Polypropylene Composites Using Agricultural Residues and Waste Fish. Compos. B Eng. 2014, 56, 279–283. [Google Scholar] [CrossRef]
- Mansouri, A.; Ben Nasr, J.; Ben Amar, M. Biocomposites Based on Polypropylene and Agave Fibers (Agave americana L.): Investigation on Physical, Thermal and Mechanical Properties. Polym. Bull. 2024, 81, 12819–12840. [Google Scholar] [CrossRef]
- Jurado-Contreras, S.; Navas-Martos, F.J.; Rodríguez-Liébana, J.A.; Moya, A.J.; La Rubia, M.D. Manufacture and Characterization of Recycled Polypropylene and Olive Pits Biocomposites. Polymers 2022, 14, 4206. [Google Scholar] [CrossRef]
- Raghu, N.; Kale, A.; Chauhan, S.; Aggarwal, P.K. Rice Husk Reinforced Polypropylene Composites: Mechanical, Morphological and Thermal Properties. J. Indian Acad. Wood Sci. 2018, 15, 96–104. [Google Scholar] [CrossRef]
- Agarwal, J.; Mohanty, S.; Nayak, S.K. Valorization of Pineapple Peel Waste and Sisal Fiber: Study of Cellulose Nanocrystals on Polypropylene Nanocomposites. J. Appl. Polym. Sci. 2020, 137, 49291. [Google Scholar] [CrossRef]
- Naghmouchi, I.; Espinach, F.X.; Mutjé, P.; Boufi, S. Polypropylene Composites Based on Lignocellulosic Fillers: How the Filler Morphology Affects the Composite Properties. Mater. Des. 2015, 65, 454–461. [Google Scholar] [CrossRef]
- Włodarczyk-Fligier, A.; Polok-Rubiniec, M.; Chmielnicki, B. Polypropylene-Matrix Polymer Composites with Natural Filler. Arch. Metall. Mater. 2021, 66, 313–319. [Google Scholar] [CrossRef]
- Hongthong, S.; Leese, H.S.; Chuck, C.J. Valorizing Plastic-Contaminated Waste Streams through the Catalytic Hydrothermal Processing of Polypropylene with Lignocellulose. ACS Omega 2020, 5, 20586–20598. [Google Scholar] [CrossRef]
- Tátraaljai, D.; Major, L.; Földes, E.; Pukánszky, B. Study of the Effect of Natural Antioxidants in Polyethylene: Performance of β-Carotene. Polym. Degrad. Stab. 2014, 102, 33–40. [Google Scholar] [CrossRef]
- Ordon, M.; Zdanowicz, M.; Nawrotek, P.; Stachurska, X.; Mizielińska, M. Polyethylene Films Containing Plant Extracts in the Polymer Matrix as Antibacterial and Antiviral Materials. Int. J. Mol. Sci. 2021, 22, 13438. [Google Scholar] [CrossRef] [PubMed]
- Lipska, K.; Betlej, I.; Rybak, K.; Nowacka, M.; Boruszewski, P. Oil Plant Pomace as a Raw Material in Technology of Sustainable Thermoplastic Polymer Composites. Sustainability 2024, 16, 7088. [Google Scholar] [CrossRef]
- EN 323:1999; Wood-Based Panels—Determination of Density. ISO: Geneva, Switzerland, 1999.
- EN 310:1994; Wood-Based Panels—Determination of Modulus of Elasticity in Bending and of Bending Strength. ISO: Geneva, Switzerland, 1994.
- EN ISO 21920-2:2022-06; Product Geometry Specifications (GPS)—Geometric Structure of Surfaces: Profile—Part 2: Terms, Definitions and Parameters of Geometric Structure of Surfaces. ISO: Geneva, Switzerland, 2022.
- EN 317:1999; Particleboards and Fiberboards—Determination of Swelling to Thickness after Immersion in Water. European for Standardization: Brussels, Belgium, 1999.
- Sanjeevi, S.; Shanmugam, V.; Kumar, S.; Ganesan, V.; Sas, G.; Johnson, D.J.; Shanmugam, M.; Ayyanar, A.; Naresh, K.; Neisiany, R.E.; et al. Effects of Water Absorption on the Mechanical Properties of Hybrid Natural Fibre/Phenol Formaldehyde Composites. Sci. Rep. 2021, 11, 13385. [Google Scholar] [CrossRef]
- Klyosov, A.A. Wood-Plastic Composites; John Wiley & Sons, Inc.: Hoboken, NJ, USA, 2007. [Google Scholar]
- Cheremisinoff, N.P. Condensed Encyclopedia of Polymer Engineering Terms; Elsevier: Amsterdam, The Netherlands, 2001; pp. 200–255. [Google Scholar]
- Smith, B. Infrared Spectral Interpretation: Systematic Approach, 1st ed.; CRC Press: Boca Raton, FL, USA, 1998. [Google Scholar]
- Maier, C.; Calafut, T. Polypropylene: The Definitive User’s Guide and Databook; Plastics Design Library; William Andrew: Norwich, NY, USA, 1998; ISBN 1884207588. [Google Scholar]
- Apaydın Varol, E.; Mutlu, Ü. TGA-FTIR Analysis of Biomass Samples Based on the Thermal Decomposition Behavior of Hemicellulose, Cellulose, and Lignin. Energies 2023, 16, 3674. [Google Scholar] [CrossRef]
- Reyes-Rivera, J.; Terrazas, T. Lignin Analysis by HPLC and FTIR. In Methods in Molecular Biology; Humana Press Inc.: Totowa, NJ, USA, 2017; Volume 1544, pp. 193–299. [Google Scholar]
- Nandiyanto, A.B.D.; Oktiani, R.; Ragadhita, R. How to Read and Interpret Ftir Spectroscope of Organic Material. Indones. J. Sci. Technol. 2019, 4, 97–118. [Google Scholar] [CrossRef]
- Bruun, S.W.; Kohler, A.; Adt, I.; Sockalingum, G.D.; Manfait, M.; Martens, H. Correcting Attenuated Total Reflection-Fourier Transform Infrared Spectra for Water Vapor and Carbon Dioxide. Appl. Spectrosc. 2006, 60, 1029–1039. [Google Scholar] [CrossRef] [PubMed]
- Deng, Z.; Xia, A.; Liao, Q.; Zhu, X.; Huang, Y.; Fu, Q. Laccase Pretreatment of Wheat Straw: Effects of the Physicochemical Characteristics and the Kinetics of Enzymatic Hydrolysis. Biotechnol. Biofuels 2019, 12, 159. [Google Scholar] [CrossRef]
- Raspolli Galletti, A.M.; D’Alessio, A.; Licursi, D.; Antonetti, C.; Valentini, G.; Galia, A.; Nassi O Di Nasso, N. Midinfrared FT-IR as a Tool for Monitoring Herbaceous Biomass Composition and Its Conversion to Furfural. J. Spectrosc. 2015, 2015, 1–12. [Google Scholar] [CrossRef]
- Lu, Y.Z.; Du, C.W.; Shao, Y.Q.; Zhou, J.M. Characterization of Rapeseed Oil Using FTIR-ATR Spectroscopy. J. Food Sci. Eng. 2014, 4, 244–249. [Google Scholar]
- Zhang, H.; Ma, J.; Miao, Y.; Tuchiya, T.; Chen, J.Y. Analysis of Carbonyl Value of Frying Oil by Fourier Transform Infrared Spectroscopy. J. Oleo Sci. 2015, 64, 375–380. [Google Scholar] [CrossRef] [PubMed]
- Alger, M. Polymer Science Dictionary; Springer: Dordrecht, The Netherlands, 2017. [Google Scholar]
- Yang, H.S.; Wolcott, M.P.; Kim, H.S.; Kim, H.J. Thermal Properties of Lignocellulosic Filler-Thermoplastic Polymer Bio-Composites. Therm. Anal. Calorim. 2005, 82, 157–160. [Google Scholar] [CrossRef]
- Legrand, N.B.R.; Lucien, M.; Pierre, O.; Fabien, B.E.; Marcel, N.P.; Jean, A.A. Physico-Chemical and Thermal Characterization of a Lignocellulosic Fiber, Extracted from the Bast of Cola lepidota Stem. J. Miner. Mater. Charact. Eng. 2020, 8, 377–392. [Google Scholar] [CrossRef]
- Majchrzak, T.; Marć, M.; Wasik, A. Understanding the Early-Stage Release of Volatile Organic Compounds from Rapeseed Oil during Deep-Frying of Tubers by Targeted and Omics-Inspired Approaches Using PTR-MS and Gas Chromatography. Food Res. Int. 2022, 160, 111716. [Google Scholar] [CrossRef]
- Kang, Q.; Appels, L.; Tan, T.; Dewil, R. Bioethanol from Lignocellulosic Biomass: Current Findings Determine Research Priorities. Sci. World J. 2014, 2014, 298153. [Google Scholar] [CrossRef]
- Kok, M.V.; Ozgur, E. Characterization of Lignocellulose Biomass and Model Compounds by Thermogravimetry. Energy Sources Part A Recovery Util. Environ. Eff. 2017, 39, 134–139. [Google Scholar] [CrossRef]
- Stokke, D.D.; Wu, Q.; Han, G. Introduction to Wood and Natural Fiber Composites; John Wiley & Sons, Ltd.: Hoboken, NJ, USA, 2013. [Google Scholar]
- Berger, C.; Mattos, B.D.; Amico, S.C.; Antonio De Farias, J.; Coldebella, R.; Gatto, D.A.; Missio, A.L. Production of Sustainable Polymeric Composites Using Grape Pomace Biomass. Biomass Convers. Biorefinery 2022, 12, 5869–5880. [Google Scholar] [CrossRef]

| Variant | Average Thickness [mm] | Coefficient of Variation [%] |
|---|---|---|
| PP_0 | 2.56 a | 3.81 |
| PP_N | 2.45 b | 2.79 |
| PE_R | 2.35 c | 1.69 |
| Variant | Average Density [kg/m3] | Coefficient of Variation [%] |
|---|---|---|
| PP_0 | 853 a | 2.46 |
| PP_N | 942 b | 2.70 |
| PE_R | 993 c | 1.51 |
Disclaimer/Publisher’s Note: The statements, opinions and data contained in all publications are solely those of the individual author(s) and contributor(s) and not of MDPI and/or the editor(s). MDPI and/or the editor(s) disclaim responsibility for any injury to people or property resulting from any ideas, methods, instructions or products referred to in the content. |
© 2024 by the authors. Licensee MDPI, Basel, Switzerland. This article is an open access article distributed under the terms and conditions of the Creative Commons Attribution (CC BY) license (https://creativecommons.org/licenses/by/4.0/).
Share and Cite
Lipska, K.; Betlej, I.; Rybak, K.; Nowacka, M.; Boruszewski, P. Characterization of Composites from Post-Consumer Polypropylene and Oilseed Pomace Fillers. Polymers 2024, 16, 3557. https://doi.org/10.3390/polym16243557
Lipska K, Betlej I, Rybak K, Nowacka M, Boruszewski P. Characterization of Composites from Post-Consumer Polypropylene and Oilseed Pomace Fillers. Polymers. 2024; 16(24):3557. https://doi.org/10.3390/polym16243557
Chicago/Turabian StyleLipska, Karolina, Izabela Betlej, Katarzyna Rybak, Małgorzata Nowacka, and Piotr Boruszewski. 2024. "Characterization of Composites from Post-Consumer Polypropylene and Oilseed Pomace Fillers" Polymers 16, no. 24: 3557. https://doi.org/10.3390/polym16243557
APA StyleLipska, K., Betlej, I., Rybak, K., Nowacka, M., & Boruszewski, P. (2024). Characterization of Composites from Post-Consumer Polypropylene and Oilseed Pomace Fillers. Polymers, 16(24), 3557. https://doi.org/10.3390/polym16243557

